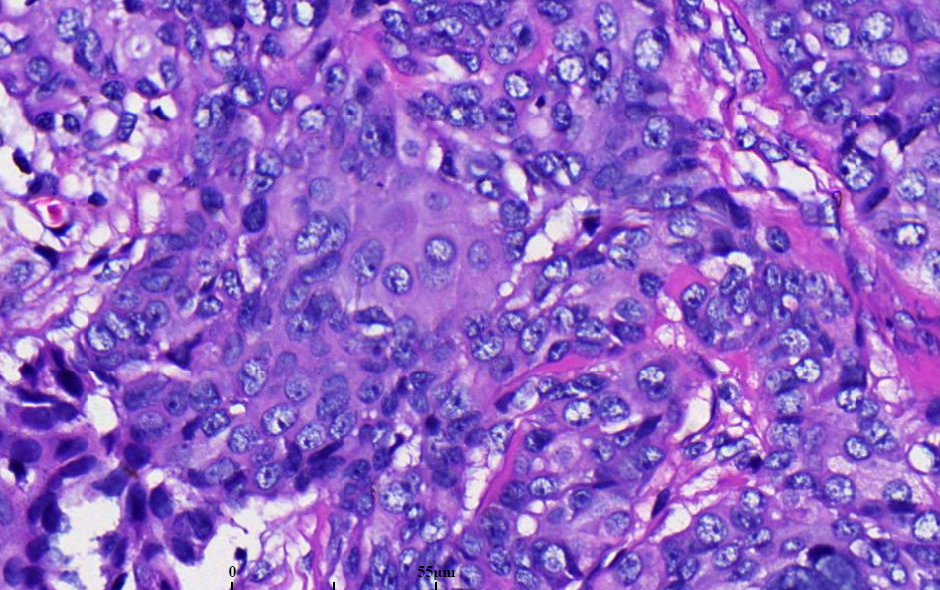

涎腺黏液表皮样癌
Mucoepidermoid carcinoma
同义词(或曾用名): 混合性表皮样和黏液分泌癌
概述:
由产黏液细胞、中间细胞和表皮样细胞构成的上皮性恶性肿瘤。
发病部位: 约一半发生在大涎腺(腮腺占 45%)。口腔内最常见的是腭和颊黏膜。
诊断要点:
黏液表皮样癌是儿童和成人最常见的原发性涎腺恶性肿瘤,患者平均年龄 45 岁,女性多见,多表现为固定的无痛性肿块;
肿瘤边界清楚或边缘有浸润,褐色、白色和粉红色。
黏液表皮样癌由表皮样细胞、产黏液细胞和中间型细胞构成。
黏液细胞:体积大,胞质苍白,核位于细胞边缘,一般少于肿瘤细胞总数的 10%。
中间型细胞:基底样或立方状,在肿瘤细胞中占多数。
表皮样细胞:呈多边形,角化罕见。
有时可见透明细胞、柱状细胞和/或嗜酸性粒细胞。
不同类型的细胞的比例和所形成的结构在肿瘤内和肿瘤间质均有不同。
坏死、间变、核分裂不同病例差异较大。
10 偶尔可见肉瘤样转化。
有学者根据形态学特点将黏液表皮样癌进行分级:低度恶性肿瘤大体为境界清楚的肿块,囊实性。镜下见大量分化良好的黏液细胞。高度恶性肿瘤多呈实性,其生长具有侵袭性。以鳞状细胞和中间型细胞为主要成分,产黏液细胞较少。也有学者对肿瘤进行评分,根据评分分级(见附表)。
当黏液表皮样癌形成的黏液或角质溢入间质组织,可引起炎症反应。肿瘤性黏液外溢常伴广泛的纤维化。
硬化性黏液表皮样癌: 少数病例可见大量纤维性间质,伴玻璃样变,可见包括嗜酸细胞在内的炎细胞浸润,有学者称之为硬化性黏液表皮样癌。
附:黏液表皮样癌的组织学特点、分级的计分方式和评分方法:
形态学特点 分值 囊性成分少于20% 2 神经侵犯 2 坏死 3 4个以上的核分裂/10个高倍视野 3 细胞间变 4 |
肿瘤分级 :0-4 分为低度恶性;5-6 分为中度恶性,7 分以上为高度恶性

免疫组织化学染色:
鳞状细胞表达高分子量角蛋白; 黏液细胞:黏液卡红、Alcia 蓝染色阳性; 透明细胞:PAS 染色阳性
分子标记:
55-65%病例有 t(11;19)(q21;p13) ,5%病例 t(11;15)(q21;q26),引起 CRTC3/MAML2 基因融合,高级别病例可有 t(6;22)(p21;q12)导致 EWSR1–POU5F1
鉴别诊断:
坏死性涎腺化生 :腺泡坏死,残存的腺导管和腺泡上皮增生,形成单层或复层上皮细胞管状结构或实性鳞状上皮团。
内翻性导管乳头状瘤 :无腺体分化,界限清楚,有钝的推进式非浸润性边缘。
鳞状细胞癌 :无产黏液细胞,黏液染色阴性。
涎腺导管癌 :常伴有罗马拱桥、粉刺样坏死,明显的核异型及分裂象多见,雄激素受体阳性,CK5/6. P63 阴性。
腺样囊腺癌:缺乏片状表皮样细胞和中间细胞,可见局灶黏液小囊,无浸润性生长。
预后:
与预后相关的参考指征包括:年龄(年轻患者预后较好)、性别(女性预后较好)、腺体外浸润、血管侵犯、核分裂。
